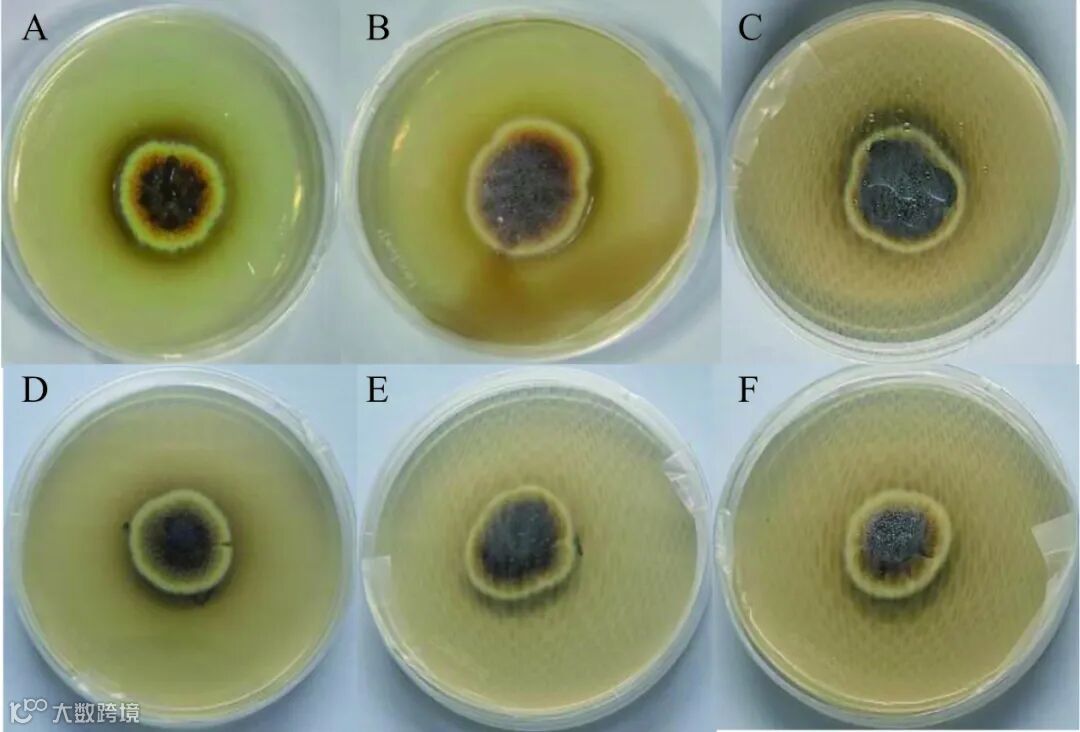

EI收录,
入选中国科技期刊卓越行动计划

摘要
为探明金花菌中冠突曲霉对发酵夏秋茶品质的影响,通过从陕西茯砖茶中分离鉴定出6株冠突曲霉,将菌株分别接种到灭菌夏秋茶中进行固态发酵,分析发酵夏秋茶的理化指标及风味变化。结果表明,发酵夏秋茶与未发酵夏秋茶(CK)相比,发酵茶整体的水浸出物含量、甜味与苦味氨基酸含量比值均显著提升(P<0.05);黄酮含量、茶多酚含量、咖啡碱含量、总儿茶素含量均显著降低(P<0.05);并且新增了25种酯类、碳氢类挥发性化合物。感官结果表明,发酵前后茶的主要香气发生了转变,发酵茶被赋予了令人愉悦的花香、果香、甜香。风味物质和感官风味特征相关性分析结果表明,花香、果香、甜香与(+)-柠檬烯、苯乙酸苯乙酯等呈正相关。综上,不同冠突曲霉发酵的夏秋茶品质存在显著差异(P<0.05),且经冠突曲霉发酵后的夏秋茶品质优于CK。另外,通过秩和比综合评价法明确冠突曲霉F改善夏秋茶的品质相对较佳。
夏秋两季采摘的茶叶统称为夏秋茶。不同于春茶产量低,夏秋茶由于受环境因素的影响,茶叶生长迅速、茶期缩短,使其占我国茶叶产量的60%左右。同时茶树受环境因素的影响,其体内碳代谢水平较高,氮代谢水平较低,使夏秋茶中氨基酸等物质含量偏低,多酚类等物质含量偏高,造成夏秋茶鲜香味淡薄,口感苦涩,与春茶相比品质不佳。最终导致大量夏秋茶因品质较差而被废弃,造成茶叶资源的严重浪费。
已有研究表明,茯砖茶中优势菌种金花菌在改善茶叶品质方面具有巨大潜力。周祎炜等将金花菌接入紫娟红茶,有效改善了茶汤的色泽和滋味,促进了茶叶中抗氧化物质的释放。徐达将金花菌接入云南普洱茶,使普洱茶苦涩味大幅降低,鲜爽度大幅提高。Zhu等将金花菌接入白茶,不仅能为白茶增加菌花香,而且能够加速白茶老化使之产生陈旧、枣香和甜味。由此可见,“金花菌”作为茯砖茶中的益生菌,可大幅改善茶叶的滋味、香味等茶叶品质,且被广泛运用于各类茶中。
目前已有一些金花菌接种改善夏秋茶品质的研究报道。Du等利用从六堡茶中分离的金花菌接入夏秋茶,能有效降低茶多酚、类黄酮等与苦涩相关的化学成分,从而降低了茶叶的苦涩味。Shen等将金花菌接入夏秋茶,为茶叶增加类似于薄荷、花香和木本香气的复合香气,显著改善了夏秋茶的风味。但现有研究主要针对金花菌中具有有性孢子的冠突散囊菌,而对金花菌中的另一类,具有无性孢子的冠突曲霉,将其接种改善夏秋茶品质的研究尚未深入。因此,本试验从陕西泾阳茯砖茶中分离鉴定出6株冠突曲霉并分别接种至灭菌后的夏秋茶中进行发酵。通过对未发酵和发酵夏秋茶的主要理化及挥发性化合物进行测定分析,探究冠突曲霉发酵夏秋茶的理化指标及风味变化,旨在为夏秋茶资源的开发与利用提供参考。

结果与分析

2.1 菌株的分离鉴定
2.2.1 菌株形态学鉴定结果
菌株在PDA培养基上的形态特征,如图1所示。中心由平坦状转为稍凸起状,质地由微弱丝状变为呈丝绒状。A、B、C菌落由淡黄色且菌落外围带少量白色孢子,变为中黑外褐边缘淡黄色且大量分生孢子表面呈炭黑色,并渗出褐黑色液。D、E、F菌落由淡黄色且菌落外围带少量白色孢子,变为中黑外灰边缘淡黄白色且大量分生孢子表面呈灰黑色,无渗出液。通过对上述菌落形态特征分析,6株菌的菌落形态特征差异不大,初步判断上述菌株为黄色近球形的真菌菌株。
图 1 菌落7 d形态特征
Figure 1. Morphological characterization of colonies after 7 days
注:A~F表示菌落A~F。
菌株在光学显微镜和扫描电镜下的形态,如图2所示。在光学显微镜下,均发现大量球形壳状结构聚集,内部包裹大量孢子,球形壳状结构破裂后可释放出内部孢子;大量盘旋缠绕状菌丝,菌丝包裹球形壳状结构且充斥之间。在扫描电镜下,大量壳状结构为囊球形或近球形,壳状结构外部有菌丝缠绕,壳状结构破裂后释放孢子;孢子呈球形、近椭球形或呈扁平状,壁明显粗糙且具有不规则的脊状突起和较平滑部。根据相关文献和《中国真菌志》中关于金花菌——冠突曲霉的形态描述,将A、B、C、D、E、F初步鉴定为冠突曲霉(Aspergillus cristatus)。

图 2 菌株7 d光学和电子显微形态结构
Figure 2. Optical and electron microscopic morphological structures of strains after 7 days
注:A~F表示菌株A~F光学显微结构,G~L表示菌株A~F电子显微结构;光学显微放大倍数400×,电子显微放大倍数1000×。
2.1.2 菌株的分子生物学鉴定结果
系统发育树如图3所示,6株优势菌均分别与冠突曲霉基因群聚集在一起。结合形态学特征和ITS基因鉴定结果,将A、B、C、D、E、F鉴定为冠突曲霉。已有研究表明,经不同冠突曲霉发酵后的茶叶品质存在差异。例如赵宏朋等用不同冠突曲霉发酵绿茶,发现发酵后绿茶的活性物质存在显著差异。为探究不同冠突曲霉发酵夏秋茶对其品质影响的差异,故对上述鉴定的冠突曲霉分别进行发酵,并对理化指标及风味进行测定分析。

图 3 菌株的ITS系统发育树
Figure 3. ITS phylogenetic tree of strains
2.2 茶叶理化指标测定结果
2.2.1 水浸出物、茶多酚和黄酮测定结果
水浸出物是茶汤中多酚类化合物、游离氨基酸等内含物的集合,其含量与茶汤的品质呈正相关,含量越高茶汤滋味越丰富,含量越低茶汤滋味越寡淡。由表1可知,经不同冠突曲霉发酵夏秋茶的水浸出物含量在21.20%~37.04%之间,其中AC-b、AC-d、AC-f水浸出物含量显著高于CK(P<0.05)。CK水浸出物含量为30.32%,发酵茶水浸出物的平均含量为31.62%,与CK相比提升了1.3%。这种变化可能是由于金花菌在生长繁殖过程中,分泌了大量的蛋白酶、纤维素酶,将茶叶中的蛋白质、纤维素等成分降解,生成了氨基酸、多酚等物质。
表 1 水浸出物、茶多酚含量和黄酮含量测定结果
Table 1. Results of aqueous leachate, tea polyphenols and flavonoids determination

注:同列不同的小写字母表示差异显著(P<0.05),表3同。
茶多酚是茶叶中的活性功能物质,同时也是茶叶中的苦味来源之一。由表1可知,CK的茶多酚含量为142.09 mg/g,经不同冠突曲霉发酵夏秋茶中的茶多酚含量在69.26~135.17 mg/g之间,整体上发酵夏秋茶的茶多酚含量均显著低于CK(P<0.05)。这可能是由于随着金花菌发花程度的加深,分泌的过氧化酶、多酚氧化酶等物质使茶多酚降解,最终导致其含量降低。发酵夏秋茶中茶多酚含量大小为:AC-e>AC-b>AC-f>AC-c>AC-d>AC-a。其中AC-e的茶多酚含量降低幅度最大(降低51.25%);而AC-a降低幅度最小(降低4.87%)。这可能由于不同金花菌生长过程中分泌的纤维素酶和多酚氧化酶的数量有关,纤维素酶可将茶叶中的纤维素分解,为金花菌的生长提供能量,而多酚氧化酶可将多酚类物质向小分子物质转换。
黄酮类化合物普遍具有涩味,其含量的高低与茶叶品质密切相关。由表1可知,CK黄酮含量为11.08 mg/g,经不同冠突曲霉发酵夏秋茶中黄酮的含量在6.23~10.98 mg/g之间,整体上发酵夏秋茶的黄酮含量均显著低于CK(P<0.05)。这可能是由于金花菌产生胞外酶可转化降解茶叶中的黄酮类物质,从而使之含量降低。发酵夏秋茶黄酮类化合物含量的下降幅度:AC-b>AC-f>AC-d>AC-e>AC-c>AC-a。其中AC-b的降低幅度最大(降低43.79%);而AC-a的降低幅度最小(降低0.96%)。
2.2.2 游离氨基酸测定结果
氨基酸与茶叶品质息息相关,其含量的高低影响茶汤鲜爽度和醇厚感。由表2可知,CK总游离氨基酸含量为13.88 mg/g,发酵茶的总游离氨基酸含量在2.19~11.16 mg/g之间,整体上发酵夏秋茶的总游离氨基酸含量均显著降低(P<0.05)。这与现有研究结果类似,茯砖茶和普洱茶发酵后氨基酸含量均呈下降趋势。这可能是由于在发酵过程中随着微生物生长,氨基酸与亚硝酸、还原糖等羧基类物质发生反应并进行转换,从而使得氨基酸含量下降。
表 2 各类氨基酸含量及比值
Table 2. Content and ratio of various amino acids

根据氨基酸的风味不同可将其分为:鲜味氨基酸(Asp、Glu)、甜味氨基酸(Ser、Gly、Thr、Ala、Pro)、苦味氨基酸(Val、Ile、Leu、Tyr、Phe、Lys、Arg、His)和无味氨基酸(Met、Cys)。有研究结果表明,茶汤滋味的变化与氨基酸的变化有极显著关系,通过降低苦味氨基酸能降低茶叶的苦涩味,增加鲜味、甜味氨基酸能提升茶叶的鲜爽和甘甜味。由表2和表3可知,与CK相比,经不同冠突曲霉发酵夏秋茶中各类氨基酸的含量均显著下降(P<0.05)。CK游离氨基酸中Asp、His、Pro的含量较高,浓度均超过1.70 mg/g;苦味氨基酸占主导地位含量为5.99 mg/g,鲜味、甜味和无味游离氨基酸含量分别为3.99、2.82、1.05 mg/g。发酵后夏秋茶的各类游离氨基酸含量平均下降幅度:苦味氨基酸>鲜味氨基酸>甜味氨基酸>无味氨基酸,其中Asp、Pro、Arg含量平均下降幅度最大均超过80%。上述氨基酸含量的变化可能与发酵过程中微生物对肽和蛋白质的降解,以及利用的氨基酸差异性有关。进一步通过甜味与苦味氨基酸含量比值可得,CK的甜苦比为47.15%;发酵茶的甜苦比在33.18%~92.77%之间,平均甜苦比为54.34%,与CK相比提升了7.19%。这种变化可能是由于发酵中苦味氨基酸下降幅度大于甜味氨基酸,从而导致发酵后甜苦比的提升,同时也表明了发酵后茶叶的品质有所提升。不同发酵茶中的甜苦比存在显著差异(P<0.05)。其中AC-f的比值最大(92.77%),AC-b的比值最小(33.18%)。表明了不同冠突曲霉发酵夏秋茶的品质存在差异。
表 3 游离氨基酸测定结果
Table 3. Results of free amino acid determination

注:同行不同的小写字母表示差异显著(P<0.05),表4~表5同。
2.2.3 儿茶素和咖啡碱测定结果
儿茶素是茶叶中的天然活性物质,也是影响茶汤苦涩度的主要因素之一。由表4可知,CK儿茶素总含量为30.83 mg/g,经不同冠突曲霉发酵夏秋茶中儿茶素的总含量在15.29~25.12 mg/g之间。整体上发酵夏秋茶中儿茶素的总含量均显著降低(P<0.05)。有研究表明,儿茶素的降低可减少茶叶的苦涩,即儿茶素降解后可在菌株分泌的单宁酶及多酚氧化酶等胞外酶的作用下形成茶褐素等水溶性物质,而茶褐素、茶红素、茶黄素的形成有利于降低茶汤苦涩度。
表 4 儿茶素和咖啡碱测定结果
Table 4. Results of catechin and caffeine determination

儿茶素可分为酯型儿茶素和非酯型儿茶素,其中酯型儿茶素(EGCG、ECG)具有较强的涩味,收敛性强;非酯型儿茶素(EC、EGC、C)稍有涩味,收敛性弱。由表4可知,未发酵夏秋茶的酯型与非酯型儿茶素含量分别为21.71 mg/g和9.11 mg/g,经不同冠突曲霉发酵夏秋茶的酯型与非酯型儿茶素含量分别在6.86~17.40 mg/g和7.72~9.01 mg/g之间。整体上发酵夏秋茶中酯型与非酯型儿茶素的含量均呈下降趋势,但下降幅度不同。酯型儿茶素在发酵过程中平均降幅为8.98 mg/g,而非酯型儿茶素在发酵过程中平均降幅仅为0.82 mg/g。这与罗密等的研究相似,即在环境和微生物的影响下,通过异构化、氧化等反应,酯型儿茶素会降解转化成非酯型儿茶素,从而导致二者降幅不同。
咖啡碱与茶叶中的滋味品质密切相关,其含量的降低能减少茶叶中的苦涩,增加醇厚和鲜爽感。由表4可知,CK咖啡碱含量为19.91 mg/g,经不同冠突曲霉发酵夏秋茶的咖啡碱含量在18.32~19.26 mg/g之间。整体上发酵夏秋茶中咖啡碱的含量均显著下降(P<0.05),这可能与金花菌在生长代谢过程中利用咖啡碱,使其含量减少有关。此外,经不同冠突曲霉发酵夏秋茶间的咖啡碱含量也存在显著差异(P<0.05),其中AC-c的降低幅度最小(降低3.24%);而AC-a的降低幅度最大(降低7.98%)。
2.3 挥发性化合物测定结果
2.3.1 挥发性化合物综合分析
采用顶空固相微萃取-气相色谱-质谱(HS-SPME-GC-MS)对未发酵和经不同冠突曲霉发酵夏秋茶的挥发性化合物进行测定,如表5所示共测定出66种挥发性化合物。其中23种酯类、16种酮类、9种醇类、10种酸醛酚类、8种碳氢类化合物。与CK相比,发酵夏秋茶共有的挥发性化合物减少12种,这些化合物主要提供青草香、油脂味、蘑菇味等气味;新增挥发性化合物41种,这些化合物主要提供花香、果香、甜香等气味。有研究表明,在金花菌发酵过程中,减少的化合物会转化成新增的化合物如α-紫罗兰酮、β-紫罗兰酮、香叶基丙酮,这类新增的化合物可能与菌花香气的形成有关。
表 5 挥发性化合物的测定结果(μg/kg)
Table 5. Determination of volatile compounds (μg/kg)



注:ND表示未检出。
进一步采用(PLS-DA)对挥发性化合物进行综合分析。由图4所示,建立的模型优秀(R2Y=0.995,Q2=0.971;R2=0.1671,Q2=−0.9015),CK和各发酵茶具有良好的区分度。值得注意的是,CK与各发酵茶间的距离较远,说明CK与各发酵茶的香气成分差距较大。发酵茶AC-a、AC-b、AC-c间相聚较近,发酵茶AC-d、AC-e、AC-f间相聚较近,说明AC-a、AC-b、AC-c间的香气成分差距较小,AC-d、AC-e、AC-f间的香气成分差距较小。此外,为确定影响茶叶香气的重要物质,利用VIP>1设立阈值对挥发性化合物进行筛选,如表6所示共筛选出21种差异挥发性化合物。

图 4 PLS-DA模型(A)与交叉验证模型(B)
Figure 4. PLS-DA model (A) and cross-validated model (B)
表 6 差异挥发性化合物筛选结果
Table 6. Differential volatile compounds screening results

2.3.2 挥发性化合物分类分析
如图5所示,在CK挥发性化合物的分类中,醇类、酯类化合物占比最大,其次是酮类、碳氢类和酸醛酚类化合物。从发酵茶挥发性化合物的平均占比来看,酯类化合物最大,酸醛酚类化合物最小。发酵后酮类、醇类化合物占比有所下降,而酯类、碳氢类占比明显提升。酯类的增加可能源于冠突曲霉通过苯丙氨酸代谢途径生成,如水杨酸甲酯。水杨酸甲酯呈冬青油、草药香气,被认为是茯砖茶“菌花香”的关键组分。另一方面,碳氢类的增加可能是由于冠突曲霉通过萜类代谢途径合成,如月桂烯、γ-松油烯。这些新形成的碳氢类化合物呈花香、果香,从而赋予了茶叶更加丰富的风味。

图 5 挥发性化合物分类
Figure 5. Volatile compounds classification
注:不同小写字母表示差异显著(P<0.05)。
通过对评茶员选择的6种具有代表性香气属性词和香气强度进行统计。最终确定了木质味、水果味、花香味、甘草味、甜味、油脂味六种香气。强度结果如图6所示,CK中木质味、甘草味、油脂味为主要香气,发酵夏秋茶中水果味、花香味、甜味为主要香气。结果表明,夏秋茶经冠突曲霉发酵后主要香气发生转变,并被赋予了令人产生愉悦的花香、果香和甜香;经不同冠突曲霉发酵的夏秋茶,其香气强度存在差异。

图 6 感官风味雷达图
Figure 6. Radar chart of sensory flavor

图 7 挥发性化合物与感官风味特征相关性热图
Figure 7. Heat map of correlation between volatile compounds and organoleptic flavor profile
表 7 秩和比综合评价法分档排序结果
Table 7. Results of the rank-ratio synthesized evaluation method for the ranking of the grades



Citation:YANG Zhichao, ZHENG Xuandong, SUN Tianze, et al. Effect of Fermentation of Aspergillus cristatus on Physicochemical Indexes and Flavors of Summer and Autumn Tea[J]. Science and Technology of Food Industry, 2025, 46(17): 35−46. (in Chinese with English abstract). doi: 10.13386/j.issn1002-0306.2024100399.
基金项目:黄山市揭榜挂帅项目(JZ2022YDZJ0062);安徽省科技攻坚计划项目(202423m10050005)。


通信作者简介

或登录www.spgykj.com阅览全文。
食品科学家论文汇总(点击专家姓名,查看论文)













《食品工业科技》特邀主编专栏征稿
《食品工业科技》特邀主编专栏征稿:果蔬基料制造:基础理论,新型加工、质量控制与智能制造☚
《食品工业科技》特邀主编专栏征稿:☚
群聊:食品工业科技作者群

温
馨
提
示

我刊正式组建微信作者群,为作者提供更多的学术与论文资讯,如需进群,请联系刘老师(微信:上方二维码,电话:87244117-8062)。
版权声明










